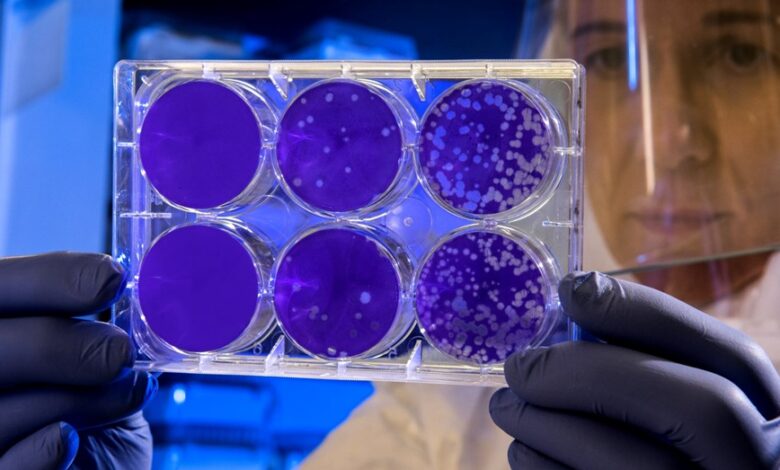

Investigadores de la UBA trabajan en la creación de órganos bioartificales para trasplantes
Otra técnica, que es complementaria con la anterior, y con cualquiera de las otras alternativas, es la de tomar el órgano del donante, quitarle las células, y luego agregarle las células del receptor, lo que lo vuelve más compatible, y permite que no se produzca un rechazo por parte del sistema inmunológico porque las ve como propias, indicó la UBA en un comunicado.
Esta última es la técnica que viene trabajando el equipo de investigadores del laboratorio de inmunomoduladores y regeneración de órganos de la Facultad de Medicina de la UBA.
«La problemática del trasplante de órganos tiene dos aristas. La principal es la escasez de donantes, seguido de cerca por la necesidad de evitar que el órgano trasplantado sea rechazado», explicó el fisiólogo e inmunólogo, Eduardo Chuluyan, docente e investigador del Conicet.
Para que un órgano no sea rechazado, hay que reducir el trabajo protector del sistema inmunológico mediante la utilización de drogas inmunosupresoras.
«La inmunosupresión lleva a un aumento de infecciones, razón por la cual la mayoría de los trasplantados suelen tener procesos infecciosos reduciendo la sobrevida del injerto y del paciente», contó el experto.
Chuluyan añadió: «La técnica que nosotros realizamos en el laboratorio es, básicamente, tomar el riñón de un animal y sacarle todas las células. Lo que queda es una especie de hormigón, la idea es reconstruir ese hormigón con otras células».
Si bien el tratamiento inmunosupresor de los trasplantados mejoró mucho para que no exista un rechazo en el corto plazo, no lo hizo en el largo plazo.
«Nos dimos cuenta tras muchos experimentos, que para conseguir que todo el órgano se volviese a completar de células, se necesitaba de una cantidad tan alta que era casi imposible y extremadamente costoso», subrayó el investigador.
En ese sentido, luego de ocho años de investigación, el equipo dirigido por Chuluyan, logró el año pasado que un riñón bioartificial, acondicionado en la mesada de su laboratorio, fuera trasplantado y funcionara in vivo produciendo orina, en tres animales diferentes.
«Pudimos probar que se podía generar un órgano acondicionado para que produzca menos rechazo en animales de laboratorio. Pasar a humanos genera diferentes problemas, desde la disponibilidad de material, a los éticos», planteó el científico.
Actualmente están trabajando en aplicar todo ese conocimiento a órganos bioartificiales que puedan ser utilizados como plataformas de pruebas de drogas y tratamientos personalizados destinados a seres humanos.
«Por ejemplo, cuando queramos probar un nuevo medicamento en un paciente, previamente podríamos construir órganos bioartificiales con las células de ese paciente, evitando ponerlo en riesgo», aclaró Chuluyan.
«Esta plataforma tiene una perspectiva a futuro de mucha utilidad, son estructuras que podrán servir para mejorar otros métodos de trasplante, como el de los xenotrasplantes (trasplantes de células, tejidos y órganos). Pero lo más importante del proyecto, es la formación de recursos humanos en técnicas de avanzada en la creación de órganos bioartificiales», completó.



